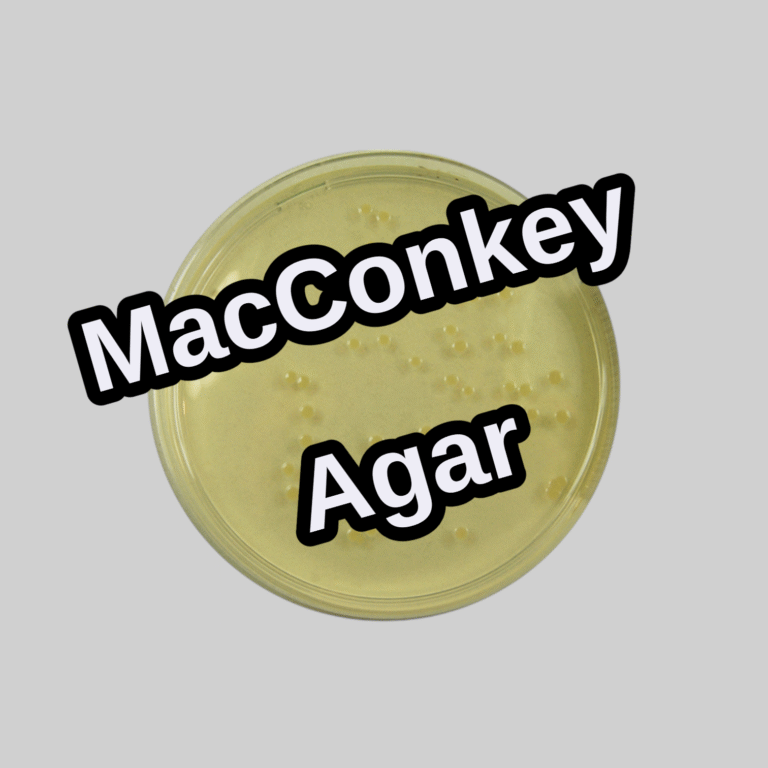

Showing all 3 results
ScienceBazar.pk offers a wide range of Microbiology Culture Media for accurate microbial growth and analysis. From nutrient agar and MacConkey agar to selective and differential media, find reliable culture media for educational, clinical, and research laboratories with nationwide delivery in Pakistan.
Microbiology Culture Media
MacConkey Agar
SKU:
13669
In stock
Nutrient Agar
SKU:
13660
In stock
Nutrient Broth
SKU:
13665
In stock